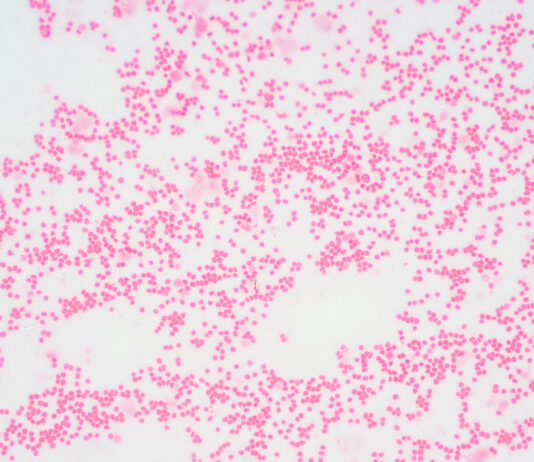
Myelofibrose: Neue Behandlungsmöglichkeiten für seltenen Blutkrebs in Sicht

GoingPublic Redaktion (um)
246 BEITRÄGE
0 Kommentare
Urs Moesenfechtel, M.A., ist seit 2021 Redaktionsleiter der GoingPublic Media AG - Plattform Life Sciences und für die Themenfelder Biotechnologie und Bioökonomie zuständig. Zuvor war er u.a. als Wissenschaftsredakteur für mehrere Forschungseinrichtungen tätig.
Diese Nachricht basiert auf einer Pressemitteilung des Innovations- und Gründerzentrum für Biotechnologie (IZB) vom 22.09.2023.
Das IZB in Martinsried veranstaltete am 21. September 2023 einen...
Galimedix Therapeutics entwickelt neue Therapieansätze gegen neurodegenerative Erkrankungen. Die Wirkstoffe sollen einen zentralen Prozess in der Pathogenese blockieren und somit die Krankheiten an der...
Ein Vierteljahrhundert „Biotechnologie“ bei GoingPublic Media: ein Meilenstein, der uns dazu veranlasst, zurückzublicken und zugleich in die Zukunft zu schauen.
Blättert man in unseren vorangegangenen...
AiCuris' Innovations-Programm AiCubator startet neue Bewerbungsrunde für innovative Projekte mit Fokus auf Behandlungsmöglichkeiten für virale Infektionen bei immungeschwächten Patiente. Die Gewinnerprojekte erhalten den AiCubator-Resident-Status...
Diese Nachricht basiert auf einer Pressemitteilung der BIO CITY LEIPZIG.
Im Jahre 2003 wurde mit der Eröffnung des Biotechnologie- und Gründerzentrums BIO CITY LEIPZIG der...
Die Medizin hat sich in den letzten Jahren rasant weiterentwickelt – insbesondere im Bereich der Immuntherapien sowie der innovativen Zell- und Gentherapien. Diese vielversprechenden...
Diese Nachricht basiert auf einer Pressemitteilung des IZB.
Dr. Peter Hanns Zobel, langjähriger Geschäftsführer des Innovations- und Gründerzentrums für Biotechnologie (IZB) gab heute bekannt, dass...
Myelofibrose: Neue Behandlungsmöglichkeiten für seltenen Blutkrebs in Sicht
GoingPublic Redaktion (um) -
Diese Nachricht basiert auf einer Pressemitteilung von BIO Deutschland e.V.
Die Myelofibrose ist eine seltene, schwer zu behandelnde Form von Blutkrebs. Das Gewebe im Knochenmark...
Am Unternehmer:innen-Tag der BIO Deutschland 2023 trafen sich führende Köpfe aus der Biotechnologie-Branche, um über die Bedeutung der Biotechnologie für eine nachhaltige Zukunft und...
Diese Nachricht basiert auf einer Pressemitteilung der AiCuris AG.
Die AiCuris Anti-infective Cures AG gab heute (6.7.23) bekannt, dass es seinen strategischen Fokus zukünftig auf...